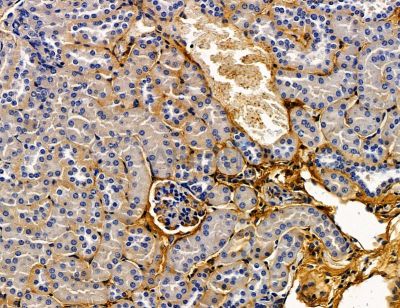
CACNB2 Antibody - DF14574 at 1/100 staining mouse kidney tissue by IHC-P.

CACNB2 Antibody - #DF14574
Related Downloads
Protocols
Product Info
*The optimal dilutions should be determined by the end user. For optimal experimental results, antibody reuse is not recommended.
*Tips:
WB: For western blot detection of denatured protein samples. IHC: For immunohistochemical detection of paraffin sections (IHC-p) or frozen sections (IHC-f) of tissue samples. IF/ICC: For immunofluorescence detection of cell samples. ELISA(peptide): For ELISA detection of antigenic peptide.
Fold/Unfold
AW060387; Ca(V) beta 2; CAB2; CACB2_HUMAN; CACNB2; CACNLB2; Calcium channel voltage dependent subunit beta 2; Calcium channel voltage-dependent subunit beta 2; Calcium channel, voltage dependent, beta 2 subunit; CAVB2; Cavbeta2; Cchb2; FLJ23743; Lambert Eaton Myasthenic syndrome antigen; Lambert Eaton myasthenic syndrome antigen B; Lambert-Eaton myasthenic syndrome antigen B; MGC129334; MGC129335; Myasthenic (Lambert Eaton) syndrome antigen B; Myasthenic syndrome antigen B; MYSB; Voltage dependent L type calcium channel subunit beta 2; Voltage-dependent L-type calcium channel subunit beta-2;
Immunogens
A synthesized peptide derived from human CACNB2.
- Q08289 CACB2_HUMAN:
- Protein BLAST With
- NCBI/
- ExPASy/
- Uniprot
MVQRDMSKSPPTAAAAVAQEIQMELLENVAPAGALGAAAQSYGKGARRKNRFKGSDGSTSSDTTSNSFVRQGSADSYTSRPSDSDVSLEEDREAVRREAERQAQAQLEKAKTKPVAFAVRTNVSYSAAHEDDVPVPGMAISFEAKDFLHVKEKFNNDWWIGRLVKEGCEIGFIPSPVKLENMRLQHEQRAKQGKFYSSKSGGNSSSSLGDIVPSSRKSTPPSSAIDIDATGLDAEENDIPANHRSPKPSANSVTSPHSKEKRMPFFKKTEHTPPYDVVPSMRPVVLVGPSLKGYEVTDMMQKALFDFLKHRFEGRISITRVTADISLAKRSVLNNPSKHAIIERSNTRSSLAEVQSEIERIFELARTLQLVVLDADTINHPAQLSKTSLAPIIVYVKISSPKVLQRLIKSRGKSQAKHLNVQMVAADKLAQCPPELFDVILDENQLEDACEHLADYLEAYWKATHPPSSSLPNPLLSRTLATSSLPLSPTLASNSQGSQGDQRTDRSAPIRSASQAEEEPSVEPVKKSQHRSSSSAPHHNHRSGTSRGLSRQETFDSETQESRDSAYVEPKEDYSHDHVDHYASHRDHNHRDETHGSSDHRHRESRHRSRDVDREQDHNECNKQRSRHKSKDRYCEKDGEVISKKRNEAGEWNRDVYIRQ
Research Backgrounds
The beta subunit of voltage-dependent calcium channels contributes to the function of the calcium channel by increasing peak calcium current, shifting the voltage dependencies of activation and inactivation, modulating G protein inhibition and controlling the alpha-1 subunit membrane targeting.
Regulated through phosphorylation at Thr-554 by CaMK2D.
Cell membrane>Sarcolemma>Peripheral membrane protein>Cytoplasmic side.
Expressed in all tissues.
Belongs to the calcium channel beta subunit family.
Research Fields
· Environmental Information Processing > Signal transduction > MAPK signaling pathway. (View pathway)
· Human Diseases > Cardiovascular diseases > Hypertrophic cardiomyopathy (HCM).
· Human Diseases > Cardiovascular diseases > Arrhythmogenic right ventricular cardiomyopathy (ARVC).
· Human Diseases > Cardiovascular diseases > Dilated cardiomyopathy (DCM).
· Organismal Systems > Circulatory system > Cardiac muscle contraction. (View pathway)
· Organismal Systems > Circulatory system > Adrenergic signaling in cardiomyocytes. (View pathway)
· Organismal Systems > Endocrine system > Oxytocin signaling pathway.
Restrictive clause
Affinity Biosciences tests all products strictly. Citations are provided as a resource for additional applications that have not been validated by Affinity Biosciences. Please choose the appropriate format for each application and consult Materials and Methods sections for additional details about the use of any product in these publications.
For Research Use Only.
Not for use in diagnostic or therapeutic procedures. Not for resale. Not for distribution without written consent. Affinity Biosciences will not be held responsible for patent infringement or other violations that may occur with the use of our products. Affinity Biosciences, Affinity Biosciences Logo and all other trademarks are the property of Affinity Biosciences LTD.